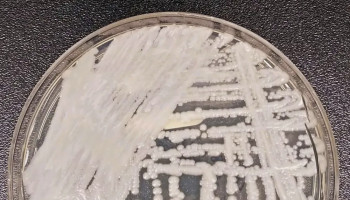

Cientistas fazem alerta sobre 'chuva' de microplástico no Ártico
Pequenas partículas do material com menos de cinco milímetros estão se espalhando ao redor do mundo
Sábado - 17/08/2019 às 10:08

NASA prepara próxima missão a Marte em campo de lava na Islândia
A ilha vulcânica do meio do Atlântico Norte tem características a fazer lembrar o planeta vermelho
Sábado - 17/08/2019 às 09:50

"Comidas do futuro" podem mudar forma dos brasileiros de se alimentar
Picanha vegetal e hambúrguer feito a partir da proteína de ervilha, soja e grão-de-bico já estão disponíveis em São Paulo.
Sábado - 06/07/2019 às 11:20

Instagram nega ouvir conversas e vigiar mensagens dos seus usuários
O executivo afirmou em entrevista com a CBS que a app da rede social não ouve as conversas dos utilizadores
Sábado - 06/07/2019 às 08:32

Eclipse solar poderá ser observado hoje na América do Sul
Uma peculiaridade tornará o evento ainda mais interessante e raro, este ano
Terça - 02/07/2019 às 12:02

Instagram desmente exposição de dados privados
Surgiram notícias que a rede social expôs os dados privados de influenciadores e celebridades
Domingo - 23/06/2019 às 09:25

Cientistas criam macacos com autismo para testar novos medicamentos
Os animais apresentam traços comportamentais e padrões de conectividade cerebral similares aos registrados em humanos
Sábado - 22/06/2019 às 16:55
Projeto de extensão estimula estudantes de escola pública a construir aeronaves não tripuladas
Os integrantes do projeto de extensão "Delta do Piauí Aerodesing" inspiram-se na cultura do "Aprender Por Meio de Projetos"
Sexta - 31/05/2019 às 12:05

Adolescente hacker que invadiu sistema da Apple só queria um emprego
O rapaz não foi identificado mas tinha apenas 13 anos quando invadiu os sistemas da empresa tecnológica de Cupertino pela primeira vez
Terça - 28/05/2019 às 13:05

XIV Congresso Piauiense Científico da FIEP - Programação completa
Podem participar profissionais e estudantes de Educação Física, Pedagogia, Educação, Fisioterapia, Turismo, Educação Artística e outras áreas afins
Segunda - 27/05/2019 às 20:05

Carro elétrico da Chevrolet começa a ser vendido em outubro no Brasil
Autonomia do Bolt EV é a maior entre os 100% elétricos em sua faixa de preço
Sábado - 25/05/2019 às 09:05

Professor desperta interesse de alunos para a confecção de foguetes
O incentivo aos alunos para a participação em olimpíadas tem gerado resultado inéditos para a escola.
Domingo - 19/05/2019 às 21:05

Plataforma online oferece preparação gratuita para o Enem
Com mais de 130 mil alunos em todo o Brasil, o "Enem Action" é uma das principais plataformas educacionais do País de preparação para o ENEM.
Sexta - 17/05/2019 às 13:05

Missão espacial chinesa desvenda segredos do lado oculto da Lua
Especula-se que a origem da Lua esteja relacionada com a colisão da Terra com um corpo celeste
Quinta - 16/05/2019 às 17:05

Usuários de smartphone devem atualizar WhatsApp, orienta empresa
Pedido é feito após falha em segurança
Quarta - 15/05/2019 às 11:05

NASA já escolheu nome para missão que levará mulher à Lua
A previsão é que a missão seja lançada em 2024
Terça - 14/05/2019 às 12:05

Uso de aplicativos de transporte reduz mortes no trânsito
O estudo, efetuado com apoio da empresa Uber, também mostrou que os aplicativos estão cada vez mais sendo usados pelas pessoas para ir ao trabalho
Terça - 14/05/2019 às 10:05

'Canindé Solar' muda a realidade do semiárido no Piauí
Nessa perspectiva, o presente projeto Canindé Solar tem por objetivo principal difundir a tecnologia de energia solar aplicada ao bombeamento no semiárido
Segunda - 13/05/2019 às 23:05

Google terá busca com realidade aumentada e audiodescrição de imagem
A adoção de realidade aumentada permitirá que o indivíduo possa também projetá-lo no local onde ele estiver
Domingo - 12/05/2019 às 11:05

Coworking: Pesquisa inédita indica melhora na produtividade para 76% dos membros
Além de rendimento, networking, disposição e qualidade de vida social e saúde são outros benefícios; Censo Coworking Brasil 2018 traça perfil dos profissionais
Sexta - 10/05/2019 às 12:05

Geotecnologias e drones vão movimentar 1,5 bi em 2019
Estimativa é da MundoGeo, que promove as duas maiores feiras do setor: DroneShow e Mundo GEO Connect, que acontecem no mês de junho em São Paulo
Terça - 07/05/2019 às 13:05

Estudantes fazem tuitaço contra os cortes na educação
Organizados pela União Brasileira de Estudantes Secundaristas (UBES), na campanha #tireamãodomeuif, estudantes de escolas em todo o Brasil enviaram vídeos
Segunda - 06/05/2019 às 19:05

Sonda japonesa faz cratera artificial em asteroide
A sonda japonesa Hayabusa2 disparou o que mais pareceu um tiro de canhão no asteroide Ryugu
Terça - 30/04/2019 às 12:04

Samsung abre inscrições para nova turma do Code IoT
Programa voltado para Internet das Coisas é 100% online e gratuito; conteúdos das aulas podem ser acessados em português, espanhol ou inglês
Segunda - 29/04/2019 às 18:04

I Jornada Científica de Biologia em Picos discute a importância da Caatinga
As discussões estão abordando as áreas da Ecologia, Botânica, Paleontologia, Zoologia, Genética, Etnobiologia e Agronomia
Quinta - 25/04/2019 às 18:04

Os robôs vão às compras - agora também no Brasil
No Brasil, a tendência global está a um passo de também ganhar realidade”, diz o engenheiro André Araújo, carioca de 42 anos
Quinta - 25/04/2019 às 14:04

Piauí contará com usinas de energia solar em barragens
A ideia é aproveitar melhor a reserva de água, gerando energia para abastecer arranjos produtivos.
Terça - 23/04/2019 às 17:04

Rovai fará palestras e lançará livro sobre novo "Ecossistema Midiático" em Teresina
A palestra e o lançamento do livro são resultados de uma parceria entre a Revista Fórum e o Portal Piauí Hoje
Segunda - 22/04/2019 às 21:04

Comitês de Bacias Hidrográficas do Piauí recebem equipamentos de informática
Nesta etapa do programa, cada um dos Comitês vai receber: uma impressora, um notebook, um projetor, um estabilizador, uma caixa de som, um microfone com fio
Segunda - 22/04/2019 às 20:04

Print nunca mais? WhatsApp pode trazer novidade que desagradaria muita gente
O aplicativo de mensagens instantâneas WhatsApp está preparando uma atualização que prevê mudanças nas modalidades de uso e que poderia restringir o print
Sexta - 19/04/2019 às 11:04

Piauí Conectado: lançado chamamento para verificação de indicadores
Empresas devem enviar propostas até o dia 15 de maio.
Quinta - 18/04/2019 às 13:04

Conheça os primeiros detalhes do novo PlayStation 5
O console de nova geração da Sony será compatível com os jogos lançados para a PlayStation 4
Quarta - 17/04/2019 às 11:04

Presos dos EUA passam a receber visitas apenas por videoconferência
Os familiares podem fazer as videoligações direto de suas residências.
Segunda - 15/04/2019 às 12:04

Após 18 anos, CorelDRAW volta ao mercado Mac
Marcando seus 30 anos de mercado, CorelDRAW Graphics Suite 2019 voa além do Windows com edições para uso na nuvem e em Apple
Sexta - 12/04/2019 às 21:04
Resistentes a Medicações: Superfungo se espalha rapidamente pelo mundo
Fungo Candida Auris já possui registro em mais de 20 países. Não há casos no Brasil
Sexta - 12/04/2019 às 15:04

Homo Luzonensis: Nova espécie humana é descoberta
Equipe multidisciplinar de cientistas descobriu uma nova espécie de hominídeo
Quinta - 11/04/2019 às 12:04

Confira a 1ª imagem de um buraco negro da história
A primeira imagem da história de um buraco negro: ele está cercado pelo brilho de gases atraídos pela gravidade
Quarta - 10/04/2019 às 16:04

Correios lançam armários inteligentes para locais sem portaria
Condomínios interessados em adquirir uma das caixas podem conferir a lista de fornecedores
Quarta - 10/04/2019 às 13:04

Aplicativo facilita a denúncia de bullying na escola
Mais de 500 pessoa já baixaram o app em um dia
Terça - 09/04/2019 às 21:04

Presidente do Twitter recebeu apenas US$ 1,40 como salário
Ele recusou todas as outras compensações e benefícios para exercer seu cargo no ano passado; em 2015, 2016 e 2017
Terça - 09/04/2019 às 15:04

Tecnologia promete remover CO2 do ar e transformar em pó
Nova tecnologia que 'captura' dóxido de carbono do ar ganhou investimentos de gigantes de combustível fóssil, mas também gera temor de ambientalistas.
Terça - 09/04/2019 às 12:04

Novo golpe no WhatsApp oferece cupom de R$ 50 no McDonald's
De acordo com o laboratório, mais de 10 mil pessoas receberam, acessaram ou compartilharam o link
Segunda - 08/04/2019 às 13:04

CR7 vira maior celebridade do Instagram no mundo
Atualmente, ele tem mais de 160 milhões de seguidores.
Sexta - 05/04/2019 às 17:04

Fóssil de baleia de 4 patas com 42 milhões de anos é encontrado
Animal tinha características semelhantes a uma lontra
Sexta - 05/04/2019 às 16:04

Estudantes deram golpe de US$ 1 milhão na Apple
Os iPhones falsos eram trazidos da China e, então, enviados para a Apple
Sexta - 05/04/2019 às 12:04

Japão causa explosão a 300 milhões de km da Terra
A missão é a mais arriscada para a Hayabusa2
Sexta - 05/04/2019 às 11:04

540 milhões de usuários do Facebook tiveram dados expostos
Até informações sobre reservas de voos e hoteis dos usuários vazaram
Quinta - 04/04/2019 às 16:04

Música eletrônica reduz reprodução e picadas do Aedes aegypti
Música do produtor Skrillex reduziu taxas de picada e reprodução dos mosquitos
Quinta - 04/04/2019 às 12:04

Coreia do Sul será primeiro país a disponibilizar 5G
Também na sexta-feira, na Coreia do Sul, será lançado o primeiro celular com capacidade para 5G da fabricante sul-coreana Samsung, o Galaxy S10 5G
Quinta - 04/04/2019 às 11:04

Cidade do Canadá começa a aceitar pagamentos com Bitcoin
Trata-se de um período de um ano, em que o novo método de pagamento será avaliado
Quarta - 03/04/2019 às 16:04